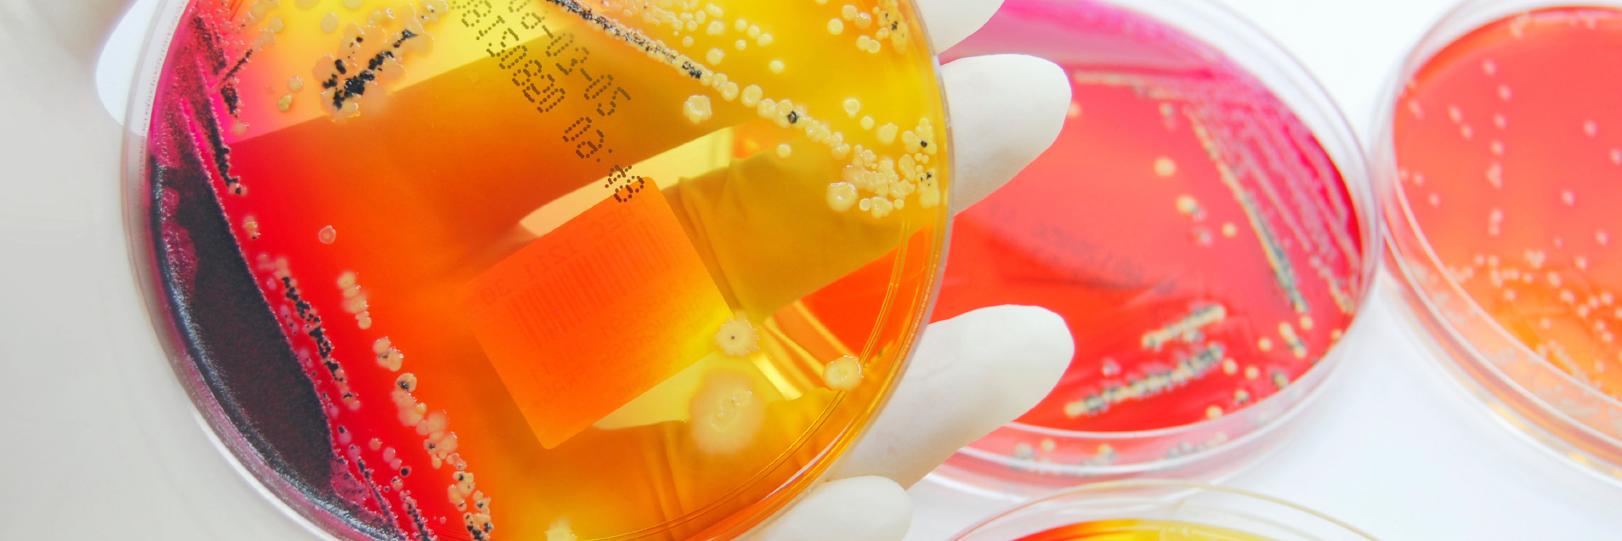
FSRIO at NAL banner

Can't wait for my new ipsy bag! Thanks Sarah! ipsy.com/new?cid=autowa…
English
FSRIO at NAL
13.4K posts

@FoodSafety
FSRIO at USDA's National Agricultural Library was created to support the research community by collecting, organizing & disseminating food safety research info.



















